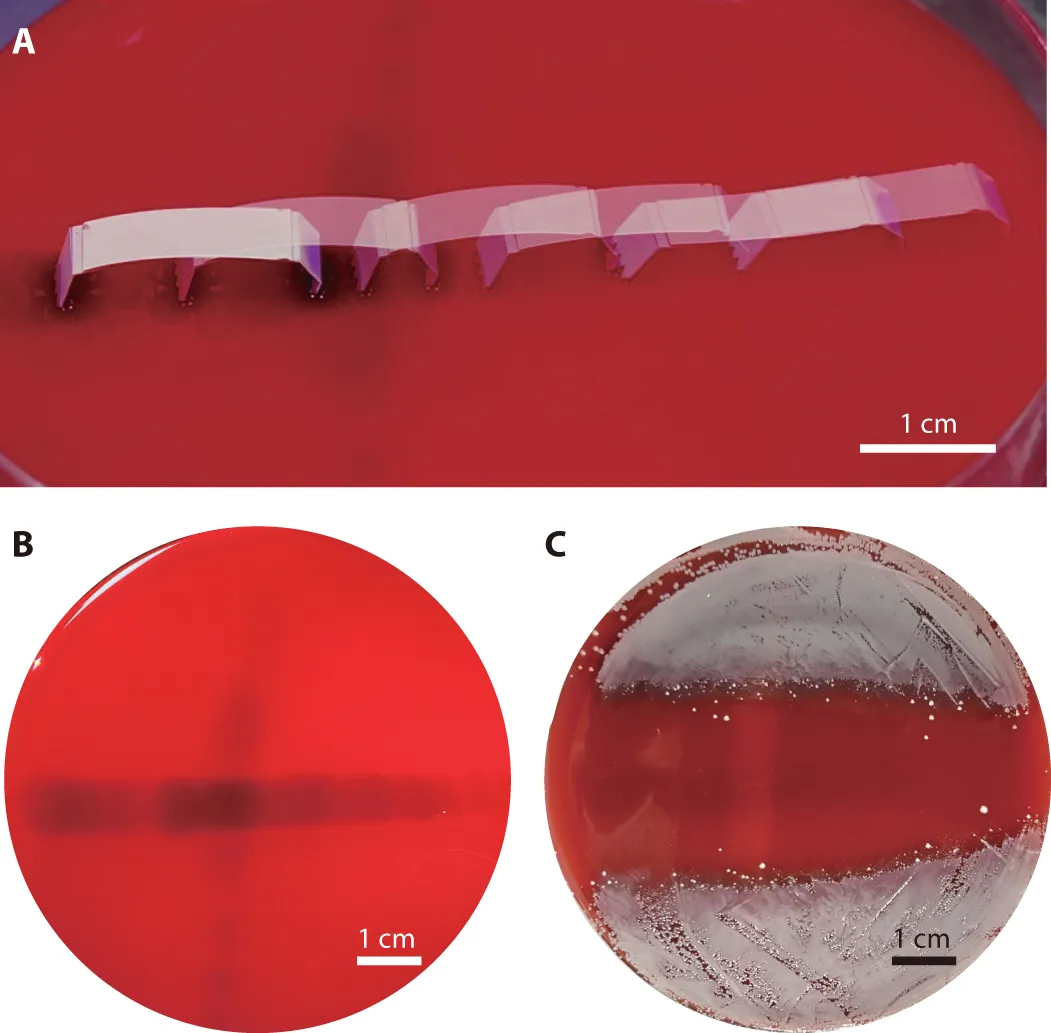

محققان رباتهایی کوچک ساختهاند که با رطوبت کار میکنند
محققان دانشگاه سئول کرهی جنوبی توانستهاند رباتهایی بسیار کوچک بسازند که با جذب رطوبت محیط طراف خود، میتوانند حرکاتی شبیه به یک کرم داشته باشند و حرکت کنند. این رباتها که Hygrobot نام گرفتهاند، میتوانند بخزند و به سمت عقب و جلو حرکت کنند. بر اساس نتایج منتشر شده از این مطالعات در نشریهی Science Robotics رباتهای کوچک ساخته شده میتوانند برای ارسال دارو به مناطق مختلف بدن استفاده شوند.
ایدهی ساخت این رباتها از گیاهان گرفته شده است.
ایدهی ساخت این رباتها از گیاهان گرفته شده است. گیاهان میتوانند شکل و اندازهی خود را با جذب آب داخل زمین یا هوا، تغییر دهند. برای مثال، درختهای کاج در روزهای بارانی بسته و در روزهای خشک، باز میشوند تا دانههای داخل خود را پخش کنند.
البته رباتها از نظر ساختار گیاهی نیستند و فقط رفتار گیاهان را شبیهسازی میکنند. این رباتها میتونند ارزش بسیار بالایی داشته باشند، چون رطوبت منبعی کاملا طبیعی از انرژی برای فعالیت آنها خواهد بود. برخلاف باتریها، که نه تنها سمی هستند، بلکه میتوانند منفجر شوند، رطوبت هیچ ضرری ندارد.

محققان یک Hygrobot را برای آزمایش وارد بشقابی پر از باکتری کردند و با خیس کردن آن با استفاده از آنتیبیوتیکها، چگونگی حرکت آن را به نمایش گذاشتند. این ربات روی صفحههای پر از باکتری از خود ردپایی به جای میگذارد و باکتریها را از بین میبرد.
منبع: The Verge
